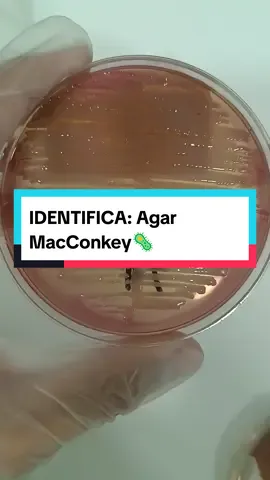

AI World
Region: PK
Wednesday 08 October 2025 15:33:42 GMT
1821
93
1
1
Music
Download
Comments
haĥjiali :
🥰🥰🥰
2025-10-08 16:38:47
0
To see more videos from user @ai.world039, please go to the Tikwm
homepage.